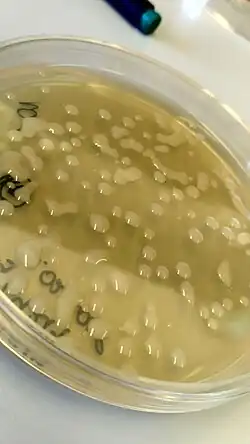

Paracoccus (bacterium)
| Paracoccus | |
|---|---|
| |
| P. yeei | |
| Scientific classification | |
| Domain: | Bacteria |
| Kingdom: | Pseudomonadati |
| Phylum: | Pseudomonadota |
| Class: | Alphaproteobacteria |
| Order: | Rhodobacterales |
| Family: | Paracoccaceae |
| Genus: | Davis 1969 (Approved Lists 1980) |
| Species and subspecies | |
|
See text | |
| Synonyms[1] | |
| |
Paracoccus is a genus of bacteria in the family Paracoccaceae (previously in the family Rhodobacteraceae).[2]
Species
Accepted species
The following species have been effectively and validly published:[1]
- Paracoccus acridae Zhang et al. 2016
- Paracoccus aeridis Rai et al. 2020
- Paracoccus aerius Xue et al. 2017
- Paracoccus aerodenitrificans Zhang et al. 2023
- Paracoccus aestuarii Roh et al. 2009
- Paracoccus aestuariivivens Park et al. 2016
- Paracoccus albicereus He et al. 2023
- Paracoccus albus Zhang et al. 2023
- Paracoccus alcaliphilus Urakami et al. 1989
- Paracoccus alimentarius Kim et al. 2018
- Paracoccus alkanivorans Zhang et al. 2020
- Paracoccus alkenifer Lipski et al. 1998
- Paracoccus aminophilus Urakami et al. 1990
- Paracoccus aminovorans Urakami et al. 1990
- Paracoccus amoyensis Lyu et al. 2021
- Paracoccus angustae Sun et al. 2015
- Paracoccus aurantiacus Ye et al. 2020
- Paracoccus bengalensis Ghosh et al. 2006
- Paracoccus caeni Lee et al. 2011
- Paracoccus carotinifaciens Tsubokura et al. 1999
- Paracoccus cavernae Dominguez-Moñino et al. 2016
- Paracoccus chinensis Li et al. 2009
- Paracoccus communis Poroshina et al. 2014
- Paracoccus contaminans Kämpfer et al. 2016
- Paracoccus denitrificans (Beijerinck and Minkman 1910) Davis 1969 (Approved Lists 1980)
- Paracoccus endophyticus Zhang et al. 2019
- Paracoccus everestensis Cui et al. 2022
- Paracoccus fistulariae Kim et al. 2010
- Paracoccus fontiphilus Sheu et al. 2018
- Paracoccus haematequi Kämpfer et al. 2019
- Paracoccus haeundaensis Lee et al. 2004
- Paracoccus halophilus Liu et al. 2008
- Paracoccus halotolerans Meng et al. 2019
- Paracoccus hibisci Yan et al. 2017
- Paracoccus hibiscisoli Lin et al. 2017
- Paracoccus homiensis Kim et al. 2006
- Paracoccus huijuniae Sun et al. 2013
- Paracoccus isoporae Chen et al. 2011
- Paracoccus kocurii Ohara et al. 1990
- Paracoccus kondratievae Doronina and Trotsenko 2001
- Paracoccus koreensis La et al. 2005
- Paracoccus laeviglucosivorans Nakamura 2015
- Paracoccus liaowanqingii Li et al. 2020
- Paracoccus lichenicola Lang et al. 2023
- Paracoccus limosus Lee and Lee 2013
- Paracoccus litorisediminis Park et al. 2017
- Paracoccus luteus Ming et al. 2020
- Paracoccus lutimaris Jung et al. 2014
- Paracoccus mangrovi Chen et al. 2017
- Paracoccus marcusii Harker et al. 1998
- Paracoccus marinaquae Xue et al. 2023
- Paracoccus marinus Khan et al. 2008
- Paracoccus methylovorus Timsy et al. 2022
- Paracoccus methylutens Doronina et al. 1998
- Paracoccus niistensis Dastager et al. 2012
- Paracoccus nototheniae Kämpfer et al. 2019
- Paracoccus onchidii Xu et al. 2024
- Paracoccus onubensis Gutierrez-Patricio et al. 2021
- Paracoccus pacificus Zhang et al. 2015
- Paracoccus panacisoli Nguyen et al. 2015
- Paracoccus pantotrophus (Robertson and Kuenen 1984) Rainey et al. 1999
- Paracoccus rhizosphaerae Kämpfer et al. 2012
- Paracoccus salipaludis Dong et al. 2018
- Paracoccus saliphilus Wang et al. 2009
- Paracoccus salsus Gao et al. 2022
- Paracoccus sanguinis McGinnis et al. 2015
- Paracoccus sediminicola Zhang et al. 2023
- Paracoccus sediminilitoris Wei et al. 2019
- Paracoccus sediminis Pan et al. 2014
- Paracoccus seriniphilus Pukall et al. 2003
- Paracoccus shanxieyensis Dong et al. 2023
- Paracoccus simplex Doronina et al. 2020
- Paracoccus solventivorans Siller et al. 1996
- Paracoccus sordidisoli Singh et al. 2017
- Paracoccus sphaerophysae Deng et al. 2011
- Paracoccus stylophorae Sheu et al. 2011
- Paracoccus subflavus Zhang et al. 2019
- Paracoccus sulfuroxidans Liu et al. 2006
- Paracoccus suum Heo et al. 2019
- Paracoccus tegillarcae Lee et al. 2019
- Paracoccus thiocyanatus Katayama et al. 1996
- Paracoccus tibetensis Zhu et al. 2013
- Paracoccus versutus (Harrison 1983) Katayama et al. 1996
- Paracoccus xiamenensis Lyu et al. 2020
- Paracoccus yeei corrig. Daneshvar et al. 2003
- Paracoccus zeaxanthinifaciens Berry et al. 2003
Provisional species
The following species have been published, but not validated according to the Bacteriological Code:[1]
- "Paracoccus aquimaris" Kim and Lee 2015
- "Paracoccus beibuensis" Zheng et al. 2011
- "Paracoccus binzhouensis" Wang et al. 2021
- "Paracoccus bogoriensis" Osanjo et al. 2009
- "Paracoccus ferrooxidans" Kumaraswamy et al. 2006
- "Paracoccus gahaiensis" Zhang et al. 2016
- "Paracoccus indicus" Lin et al. 2019
- "Paracoccus jeotgali" Kim et al. 2019
- "Paracoccus maritimus" Yu et al. 2024
- "Paracoccus mutanolyticus" Buddana et al. 2016
- "Paracoccus oceanense" Fu et al. 2011
- "Paracoccus pueri" Wang et al. 2018
- "Paracoccus ravus" Yoon et al. 2019
- "Paracoccus schoinia" Takaichi et al. 2006
- "Paracoccus shandongensis" Gong et al. 2021
- "Paracoccus siganidrum" Liu et al. 2013
- "Paracoccus thiophilus" Doronina et al. 2002
- "Paracoccus zhejiangensis" Wu et al. 2013
References
- ^ a b c Euzéby JP, Parte AC. "Paracoccus". List of Prokaryotic names with Standing in Nomenclature (LPSN). Retrieved July 20, 2024.
- ^ See the NCBI webpage on Paracoccus. Data extracted from the "NCBI taxonomy resources". National Center for Biotechnology Information. Retrieved 2007-03-19.
Further reading
Scientific journals
- Ludwig W, Mittenhuber G, Friedrich CG (1993). "Transfer of Thiosphaera pantotropha to Paracoccus denitrificans". Int. J. Syst. Bacteriol. 43 (2): 363–367. doi:10.1099/00207713-43-2-363. PMID 8494744.
- Davis DH, Doudoroff M, Stanier RY, Mandel M (1969). "Proposal to reject the genus Hydrogenomonas: Taxonomic implications". Int. J. Syst. Bacteriol. 19 (4): 375–390. doi:10.1099/00207713-19-4-375.
- Deb, Chirajyoti; Stackebrandt, Erko; Pradella, Silke; Saha, Anupama; Roy, Pradosh (June 2004). "Phylogenetically Diverse New Sulfur Chemolithotrophs of a-Proteobacteria Isolated from Indian Soils". Current Microbiology. 48 (6): 452–8. doi:10.1007/s00284-003-4250-y. PMID 15170243. S2CID 23453989.
Scientific books
- Garrity GM, Holt JG (2001). "Taxonomic Outline of the Archaea and Bacteria". In DR Boone, RW Castenholz (eds.). Bergey's Manual of Systematic Bacteriology Volume 1: The Archaea and the deeply branching and phototrophic Bacteria (2nd ed.). New York: Springer Verlag. pp. 155–166. ISBN 978-0-387-98771-2.